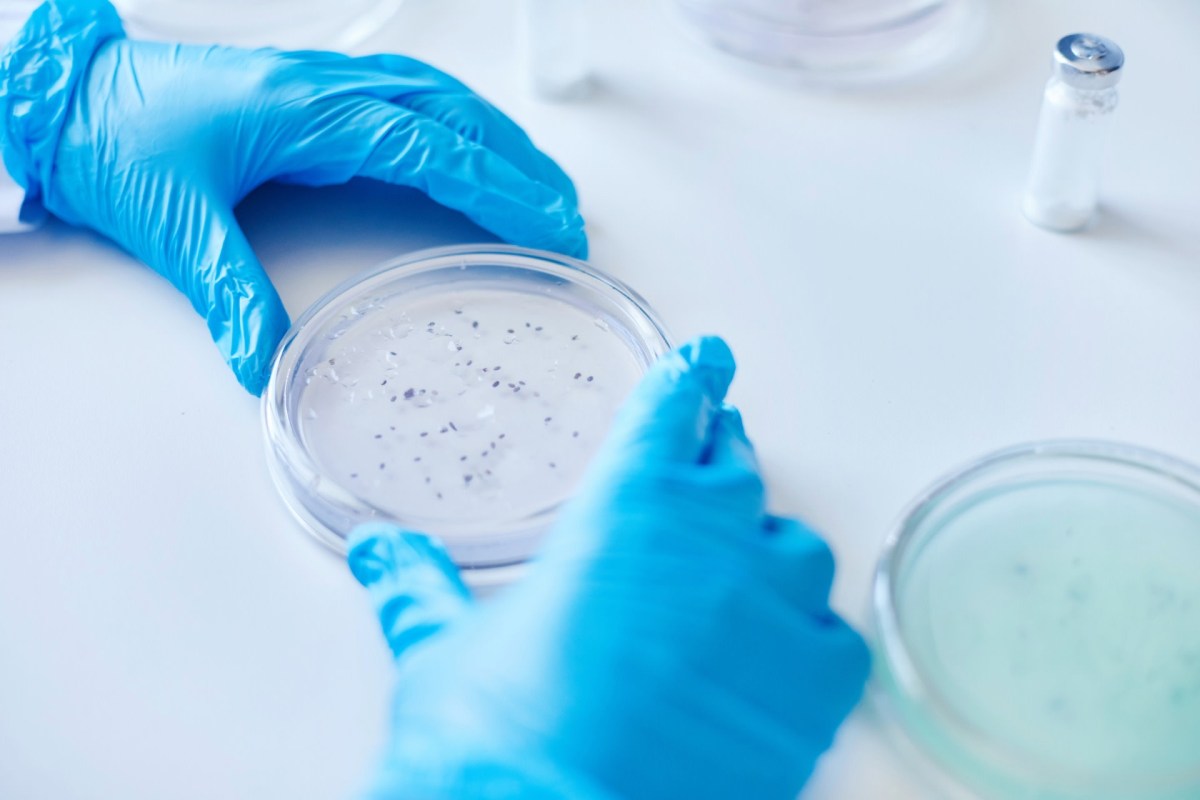
It could "pave the way toward applications in structural materials."

Researchers from a couple of American universities are corralling bacteria with shear force, giving the tiny organisms renewed purpose.
As a result, biodegradable bacterial cellulose can be transformed into a substance that has the potential to replace polluting plastic, according to a news release from the University of Houston. Scientists there are working with experts from Rice University on the project.
"We're essentially guiding the bacteria to behave with purpose. Rather than moving randomly, we direct their motion, so they produce cellulose in an organized way. This controlled behavior, combined with our flexible biosynthesis method with various nanomaterials, enables us to achieve both structural alignment and multifunctional properties in the material at the same time," Houston Assistant Professor Maksud Rahman said in the release.
At issue are the nearly 441 million tons of plastic produced globally each year. About half of it is made for single-use wares. Worse yet, less than 10% is sent to a recycler. More than 12 million tons end up in forests, lakes, rivers, and seas, all according to the United Nations.
The disposable utensils, water bottles, and other cheap, fossil fuel-based products can take hundreds of years to decompose, per the World Wildlife Fund. In the meantime, they shed microplastics that animals and humans are ingesting. Scientists are still studying how the microscopic invaders could be damaging our bodies, including reproductive issues, inflammation, and organ harm, according to Harvard Medicine.
Bacterial cellulose, an abundant biopolymer, could be the answer that spans industries.
Save $10,000 on solar panels without even sharing your phone number Want to go solar but not sure who to trust? EnergySage has your back with free and transparent quotes from fully vetted providers that can help you save as much as $10k on installation. To get started, just answer a few questions about your home — no phone number required. Within a day or two, EnergySage will email you the best local options for your needs, and their expert advisers can help you compare quotes and pick a winner. |
"We envision these strong, multifunctional and eco-friendly bacterial cellulose sheets becoming ubiquitous, replacing plastics in various industries and helping mitigate environmental damage," Rahman said in the release.
The lab work is billed as a simple, scalable strategy that biosynthesizes "robust … nanofibrils and bacterial cellulose-based multi-functional hybrid nanosheets."
A rotational cultural device leverages shear force to help make a cellulose sheet that's strong, flexible, foldable, and transparent. The spin results in a consistent directional flow, which is crucial to the process, according to Rice doctoral student M.A.S.R. Saadi. He is the study's first author.
Testing included bacteria fed with boron nitride nanosheets. The resulting bacterial cellulose-boron nitride hybrid product demonstrated even better strength and thermal properties, according to the release.
TCD Picks » Quince Spotlight
💡These best-sellers from Quince deliver affordable, sustainable luxury for all
|
Would you live in a home made of bacteria? Click your choice to see results and speak your mind. |
U.S. government experts are also turning to odd partners for plastic alternatives. Researchers at Lawrence Berkeley National Laboratory are working with E. coli to make plastic-based materials, as an example. Other scientists in the Netherlands have discovered that certain bacteria can eat plastic, which may one day help reduce the pollution burden.
Recycling is a big way to help. Services such as Recycle Check can get you started. Ditching single-use plastics is also a hack that can save you money. A $40 reusable water bottle can replace loads of throwaway ones, provide you with a better product, and save about $260 a year — all while avoiding microplastics that slough off the plastic kind.
Back in the Houston lab, the bacteria research involves multiple fields of study with numerous applications.
It could "pave the way toward applications in structural materials, thermal management, packaging, textiles, green electronics, and energy storage," Rahman said.
Join our free newsletter for weekly updates on the latest innovations improving our lives and shaping our future, and don't miss this cool list of easy ways to help yourself while helping the planet.